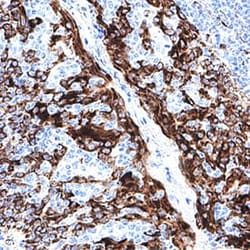
Human CKAP4/p63 Antibody, R D Systems 25 &mu;g; Unconjugated:Antibodies,

missing translation for 'onlineSavingsMsg'
Learn More
Learn More
Human CKAP4/p63 Antibody, R&D Systems™
Mouse Monoclonal Antibody
Brand: R&D Systems MAB11600-SP
This item is not returnable.
View return policy
Description
CKAP4/p63 Monoclonal antibody specifically detects CKAP4/p63 in Human samples. It is validated for Western Blot,Simple Western,Immunohistochemistry,Immunocytochemistry
Specifications
| CKAP4/p63 | |
| Monoclonal | |
| Unconjugated | |
| Lyophilized from a 0.2 μm filtered solution in PBS with Trehalose. | |
| 63 kDa membrane protein, CLIMP-63, cytoskeleton-associated protein 4, ERGIC-63, MGC99554, P63, transmembrane protein (63kD), endoplasmic reticulum/Golgi intermediatecompartment, type-II transmembrane protein p63 | |
| Mouse myeloma cell line, NS0-derived human CKAP-4, His128-Val602, Accession # Q07065 | |
| 25 μg | |
| Primary | |
| Reconstitute lyophilized material at 0.2 mg/mL in sterile PBS. For liquid material, refer to CoA for concentration. | |
| Use a manual defrost freezer and avoid repeated freeze-thaw cycles. 12 months from date of receipt, -20°C to -70 °C as supplied. 1 month, 2 to 8 °C under sterile conditions after reconstitution. 6 months, -20°C to -70 °C under sterile conditions after reconstitution. | |
| IgG |
| Western Blot, Simple Western, Immunohistochemistry, Immunocytochemistry | |
| 1086526 | |
| Western Blot 1 μg/mL, Simple Western 4 μg/mL, Immunohistochemistry 3-25 μg/mL, Immunocytochemistry 3-25 μg/mL | |
| Q07065 | |
| Mouse | |
| Protein A or G purified from hybridoma culture supernatant | |
| RUO | |
| 10970 | |
| Human | |
| Purified |
Product Content Correction
Your input is important to us. Please complete this form to provide feedback related to the content on this product.
Product Title
Spot an opportunity for improvement?Share a Content Correction